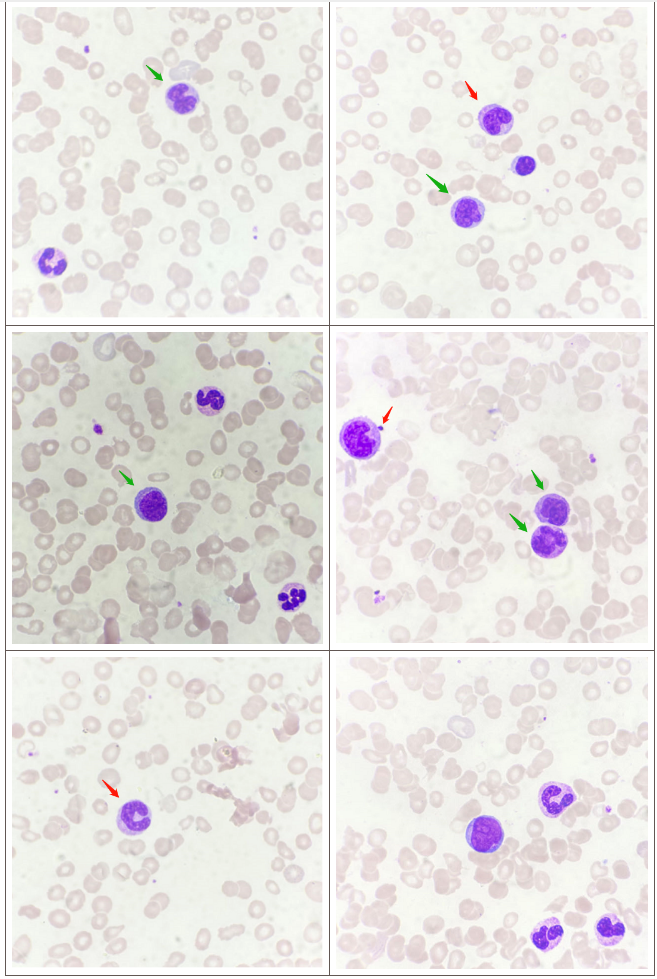
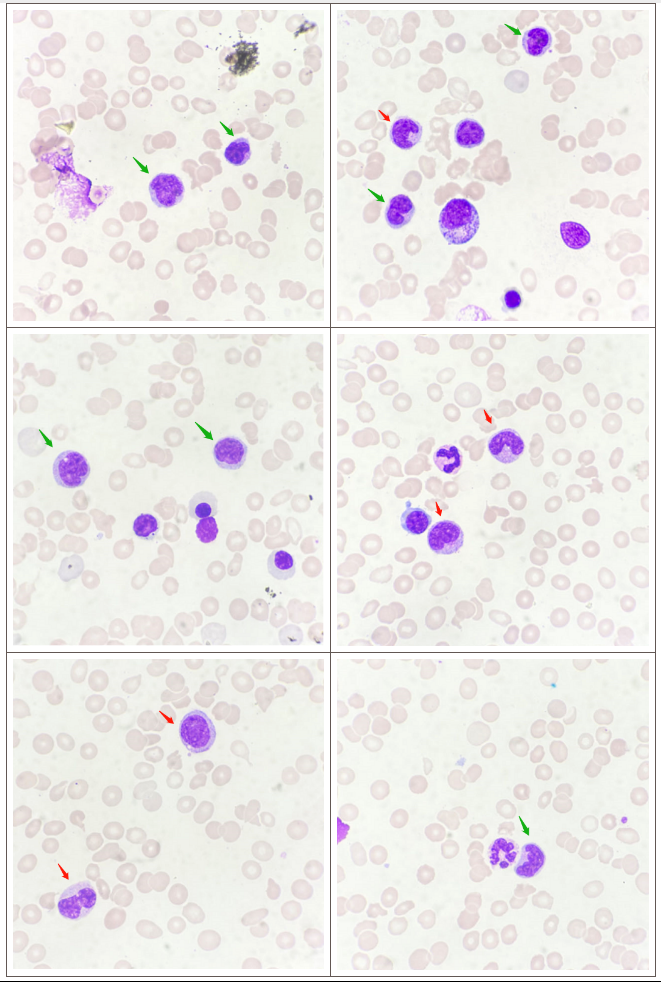

李红森 | 贵港市妇幼保健院
指导老师 | 袁凯旋 广东省人民医院检验科
01 前 言
未成熟单核细胞是慢性粒单核细胞白血病(CMML)单独拥有的名词,其独特的细胞形态学特征对疾病的筛查和诊断具有重要意义。
02 案例经过
患者,男,75岁,2月前新冠感染康复后自觉食欲较前下降,减至一半,无腹痛、腹胀、恶心呕吐、腹泻等消化道症状。未予诊治,随后出现体重逐渐下降,于2023年7月到当地医院就诊。CT提示:“回肠下段及回盲部肠壁增厚并局部肠套叠”,怀疑肿瘤性病变。患者为进一步明确诊断来我院就诊。血常规检验结果见图1:


图1
患者血常规:WBC:13.09×10^9/L↑,HB:77g/L↓,RBC:2.81×10^12/L↓,PLT:42.0×10^9/L↓,单核细胞计数6.51×10^9/L↑,单核细胞百分比49.7%↑。散点图提示幼稚细胞、成熟单核细胞增多。
血片镜检见图2:
图2 绿色箭头考虑为未成熟单核细胞、红色箭头成熟单核细胞
血片意见:白细胞偏多,分类可见早幼粒以下各阶段,嗜酸嗜碱细胞可见,单核细胞占30%(其中不成熟单核细胞占20.0%),原始细胞占1.0%,成熟红细胞大小不一,可见大红、小红、椭圆形和碎裂形红细胞,分类100个白细胞可见3个有核红细胞。
骨髓细胞学镜检及结果见图3~4。
图3 绿色箭头考虑为未成熟单核细胞、红色箭头成熟单核细胞

图4
意见:骨髓增生尚活跃,嗜酸嗜碱细胞可见,可见病态造血,原始细胞4.0%,外周血占1.0%,可见幼红幼粒,单核细胞比例增高,符合慢性粒—单核细胞白血病骨髓象。
03 案例分析
慢性粒-单核细胞白血病(Chronic myelomonocytic leukemia, CMML)是最常见的骨髓增生异常综合征/骨髓增殖性肿瘤(MDS/MPN),年发病率为(3~4)/10万。CMML患者的骨髓象中,单核细胞通常具有4个不同阶段的细胞,分别是原始单核细胞、幼稚单核细胞、未成熟单核细胞和成熟单核细胞。
其中原始单核和幼稚单核统称为原始细胞,不做区分。由于不成熟单核细胞在CMML中具有典型的形态学特征,如果将不成熟单核细胞计入幼稚细胞将会导致原始细胞比例增高,造成误诊。
不成熟单核细胞是一类介于幼稚和成熟阶段单核细胞(图5竖二排),具有以下几个特点[1]:核桨比较大、核不规则扭曲、染色质不均与聚集、胞质颗粒异常,嗜碱性介于原幼单核细胞和成熟单和细胞之间,胞浆与同一骨髓或外周血中成熟的单核细胞比较颜色更深。
不成熟单核细胞属于较成熟阶段的单核细胞,在希森美康XN系列仪器中与成熟细胞统一划为一类细胞。另外,当原始细胞比例较低时,血常规散点图不会出现较大的异常,不易引起检验人员的重视(见图1)。

图5
典型的慢性粒单核细胞白血病必须具备[2]:持续(≥3个月)外周血单核细胞增多≥1×10^9/L,且白细胞分类计数单核细胞比例>10%;排除BCR-ABL1+白血病、经典的MPN和所有其他可能导致慢性持续单核细胞增多的骨髓肿瘤、外周血和骨髓涂片中的原始细胞计数<20%;排除所有其他可作为AML证据的组织病理学、形态学、分子和细胞遗传学特征。
指南并未涉及到不成熟单核细胞的描述,不过,国外却很早就已经有不成熟单核细胞的描述了,且定义了不成熟单核细胞在CMML诊断中具有重要的作用。本案例患者血常规提示重度贫血,血小板降低,单核细胞比例增高,可见较多不成熟单核细胞,结合血液细胞形态及患者的各项检查,CMML诊断明确。
实际工作中,不成熟单核细胞辨别确是一个难点,只有通过与血片或骨髓片中的成熟单核细胞比较,才比较好区分。因此对于血常规初筛而言,遇到血常规异常伴单核细胞增多的样本,一定要排除有无CMML可能。
04 心得体会
CMML是一类少见病,由于疾病进展缓慢,发病多属老年患者,漏诊或误诊时有发生。借助外周血细胞的特殊形态特征,可以通过外周血镜检做到疾病的常规筛查。
[参考文献]
[1]Goasguen JE,Bennett JM,Bain BJ.Morphological evaluation of monocytes and their precursors.[J].Haematologica,2009,94(7):994-997.
[2]中华医学会血液学分会白血病淋巴瘤学组.慢性粒-单核细胞白血病诊断与治疗中国指南(2021年版)[J].中华血液学杂志,2021,42(1):5-9.